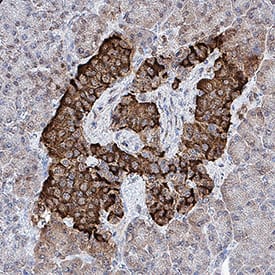

Human/Mouse Proinsulin Antibody
R&D Systems, part of Bio-Techne | Catalog # MAB13361


Key Product Details
Species Reactivity
Validated:
Cited:
Applications
Validated:
Cited:
Label
Antibody Source
Product Specifications
Immunogen
Phe25-Asn110
Accession # P01308
Specificity
Clonality
Host
Isotype
Scientific Data Images for Human/Mouse Proinsulin Antibody
Proinsulin in beta TC-6 Mouse Cell Line.
Proinsulin was detected in immersion fixed beta TC-6 mouse beta cell insulinoma cell line using Mouse Anti-Human/Mouse Proinsulin Monoclonal Antibody (Catalog # MAB13361) at 10 µg/mL for 3 hours at room temperature. Cells were stained using the NorthernLights™ 557-conjugated Anti-Mouse IgG Secondary Antibody (red; Catalog # NL007) and counterstained with DAPI (blue). Specific staining was localized to cytoplasm. View our protocol for Fluorescent ICC Staining of Cells on Coverslips.Proinsulin in Human Pancreas.
Proinsulin was detected in immersion fixed paraffin-embedded sections of human pancreas using Mouse Anti-Human/Mouse Proinsulin Monoclonal Antibody (Catalog # MAB13361) at 0.5 µg/mL for 1 hour at room temperature followed by incubation with the Anti-Mouse IgG VisUCyte™ HRP Polymer Antibody (VC001). Before incubation with the primary antibody, tissue was subjected to heat-induced epitope retrieval using Antigen Retrieval Reagent-Basic (CTS013). Tissue was stained using DAB (brown) and counterstained with hematoxylin (blue). Specific staining was localized to cytoplasm and plasma membrane in islet cells. Staining was performed using our protocol for IHC Staining with VisUCyte HRP Polymer Detection Reagents.Applications for Human/Mouse Proinsulin Antibody
CyTOF-ready
Immunocytochemistry
Sample: Immersion fixed beta TC-6 mouse beta cell insulinoma cell line
Immunohistochemistry
Sample: Immersion fixed paraffin-embedded sections of human pancreas
Intracellular Staining by Flow Cytometry
Sample: betaTC-6 mouse beta cell insulinoma cell line fixed with paraformaldehyde and permeabilized with saponin
Formulation, Preparation, and Storage
Purification
Reconstitution
Formulation
Shipping
Stability & Storage
- 12 months from date of receipt, -20 to -70 °C as supplied.
- 1 month, 2 to 8 °C under sterile conditions after reconstitution.
- 6 months, -20 to -70 °C under sterile conditions after reconstitution.
Background: Proinsulin
Proinsulin is synthesized as a single chain, 110 amino acid (aa) preproprecursor that contains a 24 aa signal sequence and an 86 aa proinsulin propeptide. Following removal of the signal peptide, the proinsulin peptide undergoes further proteolysis to generate mature insulin, a 51 aa disulfide-linked dimer that consists of a 30 aa B chain (aa 25‑54) bound to a 21 aa A chain (aa 90‑110). The 34 aa intervening peptide (aa 55‑89) that connects the B and A chains is termed the C-peptide. Human proinsulin shares 84% and 80% aa sequence identity with rat and bovine proinsulin, respectively. Most of the sequence variation between species occurs in the region of the C-peptide (1). This peptide generates a structural conformation that allows for the correct formation of the intrachain disulphide bonds (1). Insulin is a molecule that facilitates the cellular uptake of glucose. This is accomplished by regulating the appearance of membrane glucose transporters. Low insulin levels or lack of insulin are associated with type 2 and type 1 diabetes mellitus, respectively. These conditions are associated with an increased risk for microvascular complications such as retinopathy, nephropathy, and peripheral neuropathy (3). Proinsulin also circulates, but its physiologic role is less well understood. It does possess about 25% of the activity of mature insulin, but it would seem unlikely to be a natural substitute for insulin (4). In type 2 diabetes, an elevated proinsulin to insulin ratio in the circulation is a well-known abnormality (5‑9). Perhaps this abnormality represents either compromised proteolytic processing or a general inability to process increased levels of insulin precursor (5). In any event, proinsulin will stimulate amylin secretion by beta-cells, and amyloid formation in pancreatic islets that promotes decreased beta cell function (10). Studies also suggest that fasting serum proinsulin may be a better predictor of future type 2 diabetes than fasting insulin levels in obese children (11).
References
- Bell, G.I. et al. (1980) Nature 284:26.
- Barbetti, F. et al. (1990) J. Clin. Endocrinol. Metab. 71:164.
- Forst, T. et al. (2008) Exp. Diabetes Res. 2008:176245.
- Steffes, M.W. et al. (2003) Diabetes Care 26:832.
- Roder, M.E. et al. (1999) Diabetes Care 22:609.
- Porte, D. Jr. (1991) Diabetes 40:166.
- Gordon, P. et al. (1974) Diabetologia 34:483.
- Saad, M.F. et al. (1990) J. Clin. Endocrinol. Metab. 70:1247.
- Roder, M.E. et al. (1995) J. Clin. Endocrinol. Metab. 80:2359.
- Dworacka, M. et al. (2006) Int. J. Clin. Pharmacol. Ther. 44:14.
- Kamoda, T. et al. (2006) Diabetes Obes. Metab. 8:192.
Alternate Names
Gene Symbol
UniProt
Additional Proinsulin Products
Product Documents for Human/Mouse Proinsulin Antibody
Product Specific Notices for Human/Mouse Proinsulin Antibody
For research use only